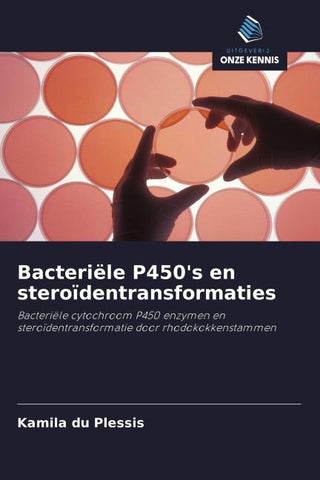
Bacteriële P450's en steroïdentransformaties

Autorenfreundlich Bücher kaufen?!

Beschreibung
Vier bacteriële cytochroom P450-enzymactiviteiten worden beschreven in termen van hun potentieel biotechnologisch gebruik voor steroïdentransformaties, door gemanipuleerde 'Rhodococcus'-stammen, in commercieel waardevolle verbindingen. Drie geselecteerde rhodococcus P450's werden gekarakteriseerd met microbiologische, genetische, biochemische, spectroscopische en chromatografische methoden. Twee sterol C26- hydroxylases werden aangetoond als belangrijk voor de afbraak van 3-hydroxysterol. De rol van de nieuwe dextromethorphan N-demethylase in het sterolmetabolisme werd besproken. Verder werd de heterologe productie van een gemuteerd P450-enzym, afkomstig van 'Bacillus megaterium', aangetoond in een gemanipuleerde 'Rhodococcus'-stam. De activiteit van het gemuteerde P450 werd geïdentificeerd als 16¿-hydroxylase van 4- androstene-3,17-dion, door ¹H en ¹³C NMR. De gedetailleerde karakterisering van de cytochroom P450-enzymen, beschreven in dit boek, geeft inzicht in het katabole repertoire van geselecteerde bacteriestammen, die nodig zijn voor de engineering van steroïde katabole paden om efficiënt geneesmiddelen te produceren.
Bacteriële cytochroom P450 enzymen en steroïdentransformatie door rhodokokkenstammen
Details
| Verlag | Uitgeverij Onze Kennis |
| Ersterscheinung | 17. März 2022 |
| Maße | 22 cm x 15 cm x 1 cm |
| Gewicht | 250 Gramm |
| Format | Softcover |
| ISBN-13 | 9786203242966 |
| Seiten | 156 |
